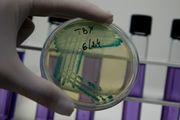

Marius B. Jørgenrud
Journalist
Jeg skriver om IT-bransjen og mange ulike temaer, blant annet digitalisering, cybersikkerhet, datasentre, personvern, kunstig intelligens, webutvikling, politikk og teknologi. Har du tips til en sak, konflikt eller god historie, ta gjerne kontakt med meg:
Tlf og Signal (kryptert): 90 85 88 19
E-post: marius@digi.no
Tlf og Signal (kryptert): 90 85 88 19
E-post: marius@digi.no
Mine artikler
14.000 har signert opprop med krav om at SXSW avlyser grunnet virusfrykt
2. mars 2020

Facebook F8 avlyst på grunn av korona
28. feb. 2020

Keith Block slutter på dagen som konsernsjef i Salesforce
26. feb. 2020

Her er Norges 50 teknologibedrifter med supervekst
25. feb. 2020

Kunstig intelligens fant nytt kraftig antibiotika
24. feb. 2020
Google sikter seg inn på kunder med stormaskin
21. feb. 2020

Datapionér Larry Tesler er død
20. feb. 2020

Amazon utvider nettskyen til norske datarom med egne serverrack
20. feb. 2020

Hva skjer egentlig når Google indekserer 38.000 falske nettsider som kobles til Helsedirektoratet?
20. feb. 2020

Amazon utvider nettskyen til norske datarom med egne serverrack
19. feb. 2020

Gir refusjon etter avlyst mobilmesse. Enkelte vil fortsatt reise til Barcelona for å avholde møter
17. feb. 2020

Gir refusjon etter avlyst mobilmesse. Enkelte vil fortsatt reise til Barcelona for å avholde møter
17. feb. 2020

Skal ruste opp nettverk ved norske flyplasser for 100 millioner – utfordreren danket ut Telenor og Atea
13. feb. 2020

Sicra ansetter ny seniorkonsulent med grått hår
13. feb. 2020

Youtube og Snapchat mest populært blant norske barn
11. feb. 2020

Posten tar i bruk 5G som erstatning for kablet nettverk. IT-direktøren tror dette er fremtiden
11. feb. 2020

Konsernsjef om cyberangrep: – Det føltes som en science fiction-film. Helt uvirkelig
10. feb. 2020

Posten tar i bruk 5G som erstatning for kablet nettverk. IT-direktøren tror dette er fremtiden
10. feb. 2020

Doble fiberbrudd slo ut flere store datasenterkunder: – En uheldig situasjon for Norge
7. feb. 2020

Doble fiberbrudd lammet deler av landet. Flere store datasenterkunder slått ut: – En uheldig situasjon for Norge
7. feb. 2020
